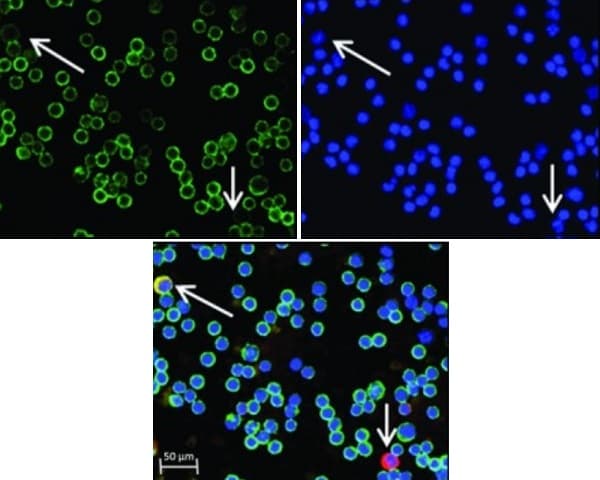
Anti-CD45 antibody [MEM-28](AB8216)
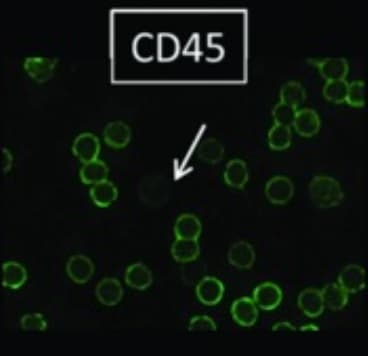
Anti-CD45 antibody [MEM-28](AB8216)

Anti-CD45 antibody [MEM-28](AB8216)
$undefined

- Antibody clone MEM-28 has been tried and trusted by researchers since 2001 and is cited in >120 publications
- One antibody for all your CD45 staining, use in CD45 western blotting, IHC, immunofluorescence and flow cytometry
| Shipped At Conditions | Blue Ice |
| Appropriate Long term Storage Conditions | Store at -20°C. |
| Clonality | Monoclonal |
| Applications | Flow Cyt, ICC/IF, IHC-P, WB |
| Species Reactivity | Human |
| Isotype | IgG1 |